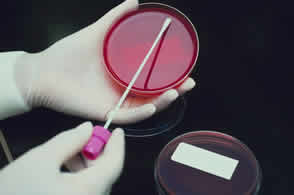

-
[常规疗法]
乳腺癌术前准备宜慎重!
日期:2011-02-26 14:59:40
点击:69745
好评:0
[常规疗法]
乳腺癌术前准备宜慎重!
日期:2011-02-26 14:59:40
点击:69745
好评:0
对乳腺癌患者,尤其年老、体弱或有各种并发症者,术前一定要作好充分准备,以保证手术的顺利进行。...
-
 [中医疗法]
手术是治疗原发肿瘤的基本方法
日期:2011-02-26 15:00:29
点击:69747
好评:0
[中医疗法]
手术是治疗原发肿瘤的基本方法
日期:2011-02-26 15:00:29
点击:69747
好评:0
法国Benoit等进行的一项回顾性研究显示,手术是治疗子宫肉瘤的基本方法,辅助化疗和放疗似乎并不能降低病变转移的危险,也不能延长患者的生存期。...
-
 [中医疗法]
中医多办法治疗肿瘤
日期:2011-02-26 15:01:19
点击:69748
好评:0
[中医疗法]
中医多办法治疗肿瘤
日期:2011-02-26 15:01:19
点击:69748
好评:0
近年来中医药治疗肿瘤的进展比较迅速,方法众多。我国各地对传统或民间治疗肿瘤单验方进行了一些研究和整理。...
-
 [中医疗法]
肿瘤的中医治疗应重视的地方
日期:2011-02-26 15:02:11
点击:69749
好评:0
[中医疗法]
肿瘤的中医治疗应重视的地方
日期:2011-02-26 15:02:11
点击:69749
好评:0
肿瘤的中医治疗目前多局限在口服和外洗、外贴等方面,肿瘤科的大夫大多数不会用针刺、艾灸等,给药途径局限,治疗方法局限,自然疗效很有限。...
-
 [中医疗法]
肺癌化疗引起的呕吐的中医治疗
日期:2011-02-26 15:03:05
点击:69750
好评:0
[中医疗法]
肺癌化疗引起的呕吐的中医治疗
日期:2011-02-26 15:03:05
点击:69750
好评:0
化疗是治疗肺癌的方法之一,化疗本身也有比较大的副作用,其中呕吐是肺癌化疗时最常见的毒副作用,严重影响着病人身心健康,影响化疗进展。...
-
 [中医疗法]
“人命”理论是攻克癌症的“要害”和关键
日期:2011-02-26 15:05:38
点击:69753
好评:0
[中医疗法]
“人命”理论是攻克癌症的“要害”和关键
日期:2011-02-26 15:05:38
点击:69753
好评:0
一百多年以来,自然科学和技术取得了日新月异、突飞猛进的发展,人类社会的政治、经济、工作和日常生活发生了翻天覆地的变化。...
-
 [中医疗法]
中医药治疗癌症有特效
日期:2011-02-26 15:06:54
点击:69755
好评:0
[中医疗法]
中医药治疗癌症有特效
日期:2011-02-26 15:06:54
点击:69755
好评:0
中医药治疗的内容十分丰富。由于中医认为肿瘤的形成与郁、淤、热、毒、虚等有关,因此扶持正气、理气活血、健脾益肾、清热解毒、滋阴清热、化痰祛湿、温阳益气等都是常用的治疗方法。...
-
 [中医疗法]
中药调理大肠癌效果佳
日期:2011-02-26 15:07:51
点击:69756
好评:0
[中医疗法]
中药调理大肠癌效果佳
日期:2011-02-26 15:07:51
点击:69756
好评:0
当前中医中药可以广泛地用于治疗肿瘤,对于许多西医治疗效果欠佳的癌症,可用中医药治疗为主。...
-
 [中医疗法]
“零毒化疗”真的那么神奇吗?
日期:2011-02-26 15:09:04
点击:69757
好评:0
[中医疗法]
“零毒化疗”真的那么神奇吗?
日期:2011-02-26 15:09:04
点击:69757
好评:0
治疗癌症一个重要的方法就是合理应用中医中药。它既有助于消除放化疗的毒副反应,同时可以避免癌症的转移复发。...
-
 [中医疗法]
中医进补有方癌肿治疗不难
日期:2011-02-26 15:10:39
点击:69758
好评:0
[中医疗法]
中医进补有方癌肿治疗不难
日期:2011-02-26 15:10:39
点击:69758
好评:0
中医认为,人体之所以患肿瘤是由于正气不足,邪毒侵袭所致。在肿瘤的发生发展的过程中,扶正治疗贯穿肿瘤治疗的整个过程。...
- 推荐内容
-
- 穿刺会导致肿瘤转移吗?
一些癌症需要穿刺来确定肿瘤的良恶性,而不少患者却担心肿瘤会因为穿刺而转移。事实上...
- 抗癌新药安体舒
该药物通过“分子双靶向作用”准确地抑杀癌细胞,对肝癌、胃 癌、乳腺癌、肺癌、宫颈...
- 中医治癌开出“奇葩”
中国大陆在民间验方及天然植物的抗癌药物发展深受国际重视,目前人体试验发现,不同种...
- 治疗癌症,中医也是半边天
西医对症治疗消灭癌细胞,中医整体治疗可减少癌细胞生成,从而控制肿瘤复发和转移。...
- 穿刺会导致肿瘤转移吗?